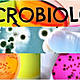
Unknown 2

-
Realiza las primeras observaciones de un microorganismo con un microscopio simple que construyo el mismo y rotulo pequeños protozoos y levaduras.
-
Demostró que la generación de gusanos en la carne eran en realidad larvas de insectos que no se presentaban si se encontraba la carne en un frasco herméticamente cerrado
-
Demostro que si se cierra herméticamente el frasco con caldo de carne después de la ebullición no aparecen microorganismos
-
Refuto definitivamente la teoría de la generación espontánea.
Pretendía demostrar que los microorganismos en caldos e infusiones llegaban a ellos adheridos a las partículas de polvo presentes en el aire y se multiplicaban en un medio rico en nutrientes.
Con su experimento al colocar el caldo en matrices y curvar el cuello del frasco con calor, hervir caldo y dejarlo reposar se mantenía libre de microorganismos indefinidamente, mientras no se inclinara el frasco. -
Se reconoció que distintos tipos de microorganismos podían causar enfermedades, en los procesos de fermentación y algunos tipos de alimentos
-
La presentación de Louis Pasteur y su informe "experiencia relativa a las generaciones llamadas espontáneas" ante la academia de las ciencias en parís puede considerarse el acta fundacional de la moderna microbiologías
-
Introdujo los términos de aeróbico y anaerobio para las levaduras según sus características de crecimiento.Y despues el termino de vacuna y virus si hacer distinción.
-
Pasteur reconoció al protozoo nosema bombycisque diezmaba a los gusanos de seda
-
considerado fundador la de la microbiología moderna y padre de la bacteriología.
propuso la clasificación de las bacterias :
genero, especie y variedad. -
establecido la relación de los microorganismos con distintas enfermedades humanas.
identifico y asilo a la especie Bacillus anthracis como causante del antrax. -
Identifica al agente causal de la gonorrea
-
Encuentra al parasito de la malaria en glóbulos rojos
-
utiliza el azul de metileno
-
Se observaron por primera vez los virus gracias a la invención del microscopio electrónico
-
Se descubrieron numerosos virus y se determinaron sus características físicas y quimicas
-
junto con su equipo descubrió los priones abriendo una vía de estudio dentro de la microbiologia(simples proteínas desprovistas de material genético.
-
Utiliza la enzima de thermus aquaticus para estabilizar la PCR
-
Interés por la teoría de la generación espontánea y por microorganismos en las enfermedades y procesos industriales .
supuso la consolidación de esta ciencia.
A list shows items. A timeline shows sequence.
Use Timetoast to make dates, milestones, and turning points easier to understand in a clear visual format. Timetoast is a timeline maker for work, school, research, and stories.